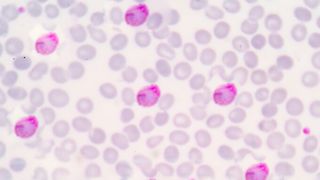
Un bărbat întors din Camerun este internat cu malarie

Un italian a fost infectat cu variola maimuței, Covid-19 și HIV în același timp
Un italian este prima persoană din lume care a fost testată pozitgiv pentru Covid-19, variola maimuței și HIV în același timp.
Cercetătorii spun că bărbatul de 36 de ani s-ar fi infectat după o călătorie în Spania la începutul acestui an. Nu a stat mai mult de cinci zile, dar se pare că a fost suficient cât să se infecteze. Acesta a recunoscut că a întreținut relații sexuale neprotejate cu un bărbat.
Citeste si: Când e recomandat să te vaccinezi antigripal. În ce perioadă este bine să te imunizezi contra gripei
A fost testat pozitiv pentru Covid la trei zile de la prezentarea simptomelor, dar a fost testat și pentru boli cu transmitere sexuală.
Pe 11 iulie, bărbatul s-a vindecat de Covid-19 și de variola maimuței, fiind externat.
Citeste si: Un bărbat întors din Camerun este internat cu malarie
Un bărbat întors din Camerun este internat cu malarie
Un bărbat de 41 de ani, întors la sfârșitul lui iulie din Camerun, a fost internat cu malarie. Bărbatul se află la Spitalul de Boli Infecțioase "Sf Parascheva" din Iași.
Citeste si: Un virus extrem de periculos fost descoperit în capitala Regatului Unit
Bărbatul s-a întors din Camerun la sfârșitul lunii iulie și prezenta simptome specifice unei viroze respiratorii, pentru care a primit tratament de specialitate de la medicul de familie.
Starea acestuia nu s-a îmbunătățit și s-a prezentat la Spitalul Municipal din Pașcani.Citeste si: 82 de copii au fost infectați cu noul virus al „gripei tomatelor”
"Acesta ne-a comunicat că a avut şi peste 40 de grade Celsius când a prezentat primele simptome.
În urma unei prime discuţii cu medicul de gardă, aflând că pacientul a revenit de curând dintr-o zonă endemică (chiar dacă a efectuat profilaxia pentru malarie) i s-au prelevat de urgenţă analize în cadrul laboratorului de analize medicale al spitalului pentru malarie iar rezultatul a fost pozitiv. Pacientul se află sub tratament curativ pentru această boală infecto contagioasă.
Citeste si: Când e recomandat să te vaccinezi antigripal. În ce perioadă este bine să te imunizezi contra gripei
Este stabil hemodinamic, i se administrează perfuzii de reechilibrare hidroelectrolitică şi este monitorizat de echipa medicală. Putem spune că a venit la timp la Spitalul Clinic de Boli Infecţioase „Sf. Parascheva” Iaşi deoarece complicaţiile malariei sunt grave: malaria cerebrală, insuficienţă multiplă de organ, cu evoluţie nefavorabilă”, arată
Jurnalistă, călătoare, optimistă. Un rezumat în trei cuvinte al Dianei Puiu.
A urmat cursuri de actorie timp de opt ani, a terminat Facultatea de Litere, Specializarea Jurnalism și Științele Comunicării din Iași, un master în Jurnalism Tematic, Facultatea de Jurnalism și Științele Comunicării, București, iar în prezent urmează cursurile programului de master Cultură și Literatură Română din cadrul Facultății de Litere Bacău.
A urmat cursurile de jurnalism de la Palatul Copiilor Bacău pe tot parcurusl liceului, experiență ce i-a adus și câteva colaborări cu presa locală.
Diana are o experiență de trei ani ca reporter de teren al unui radio din Iași și un an de prezentator de știri.
Iubește tot ce ține de teatru, film, pictură și modă, fiind și organizator de evenimente culturale. Când nu este la birou sau pe teren, Diana se relaxează în natură și face fotografii, una din pasiunile ei.